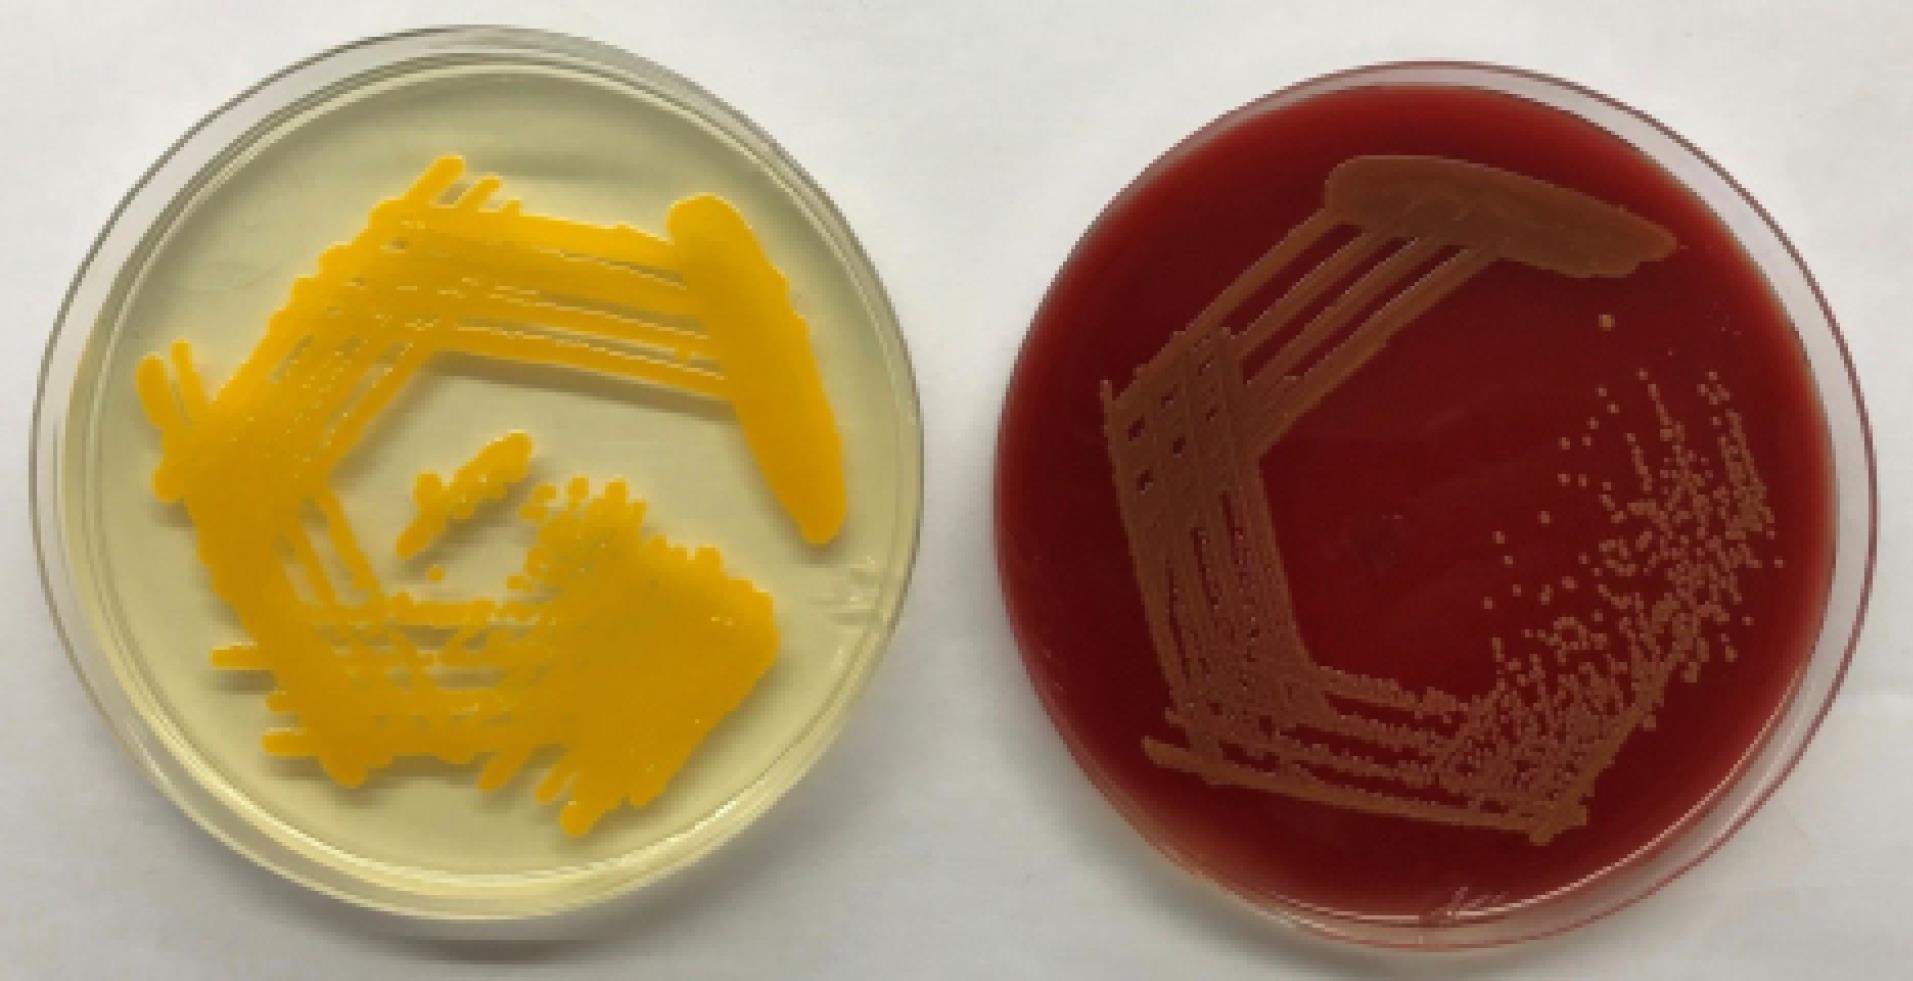
jrcm-12-3-g001

J Res Clin Med. 12:3.
doi: 10.34172/jrcm.2024.33436
Case Report
Clinical and microbiological characteristics of Chryseobacterium indologenes bacteremia: A case report and review of literature
Ayushi Jorwal Data curation, Writing – original draft, 
Pallaavi Goel Investigation, Project administration, 
Vishnu Kumar Garg Supervision, Writing – review & editing, * 
Ekadashi Rajni Conceptualization, Formal analysis, Supervision, Writing – review & editing, 
Author information:
Mahatma Gandhi University of Medical Sciences & Technology, Jaipur, Rajasthan, India
Abstract
Chryseobacterium indologenes is an uncommon human pathogen that is aerobic, non-fermentative, and oxidase and indole positive. Its clinical relevance has yet to be fully determined. An increase in deadly infectious cases has been recorded in recent years, mostly in patients of older age group and immunocompromised states as a result of C. indologenes infection of medical equipment involving fluids and implanted devices. Because C. indologenes is resistant to the majority of antibiotics, therapy is challenging and this bacterium is thought to be an emerging cause of high mortality in critically ill patients. In our study, we describe a case of C. indologenes producing bacteremia in an elderly female patient with a history of ovarian cancer and hepatitis B infection who had underwent a right hemicolectomy with end ileostomy and a distal mucus fistula and was effectively treated with levofloxacin.
Keywords: Bacteremia, Chryseobacterium indologenes, Intensive care unit
Copyright and License Information
© 2024 The Authors.
This is an open access article distributed under the terms of the Creative Commons Attribution License (
http://creativecommons.org/licenses/by/4.0/), which permits unrestricted use, distribution, and reproduction in any medium, provided the original work is properly cited.
Funding Statement
No source of funding declared.
Introduction
Chryseobacterium species, formerly known as Flavobacterium belong to the family Flavobacteriaceae.1 Chryseobacterium indologenes is an aerobic, gram negative, non-fermenting, and oxidase- and catalase-positive non-motile bacteria. Chryseobacterium is found in food, plants, and soil, and is not a part of the natural human flora.2,3 It is a rare organism that is known to infect mostly hospitalized patients with serious underlying conditions and in patient with impaired immune system. It can result in number of infections such as bacteremia, nosocomial pneumonia, biliary tract infections, peritonitis, and surgical site infections. Since C. indologenes hasn’t been regularly isolated from clinical specimens, its clinical relevance is yet to be determined. After 24 hours at 37 °C, the majority of C. indologenes strains grow well on blood agar but not on MacConkey agar.3,4 The appropriate antibiotic choice is challenging for this organism as it shows resistance to multiple antibiotics. This report describes a case of C. indologenes nosocomial septicemia in an elderly patient with hepatitis B infection & ovarian tumor and reviews previously reported infections by C. indologenes in all age groups.
Case Report
A 60-year-old female with known case of ovarian cancer and hepatitis B infection, who have undergone a right hemicolectomy with end ileostomy with distal mucus fistula one month back, presented to us with complain of vomiting and generalized weakness for five days. The vomiting was bilious in nature and contained undigested food particles; more frequent in the evening and was not associated with any abdominal pain. On examination, the patient had pallor, stable vital signs, a soft, non-tender abdomen, audible bowel sounds, and a healthy, functioning stoma with daily output of around 250–300 cc. The patient was admitted, and relevant investigations were carried out as listed in Table 1.
Table 1.
Blood parameters of patient
|
Investigations
|
Day 1 (of admission)
|
Day 7
|
Day 15
|
Day 22
|
Day 32
|
On discharge
|
| WBC (per microliter) |
9780 |
2900 |
7500 |
3200 |
6200 |
4700 |
| Haemoglobin (g/dL) |
8.6 |
8.3 |
8.1 |
8.8 |
10.6 |
9.6 |
| Platelets (per microliter) |
65000 |
105000 |
90000 |
40000 |
61000 |
196000 |
| Neutrophils |
82% |
73% |
78% |
95% |
77% |
73% |
| Sodium (mmol/L) |
133 |
139 |
138 |
140 |
135 |
131 |
| Potassium (mmol/L) |
3.9 |
2.9 |
4.5 |
3.1 |
3.4 |
3.8 |
| SGOT/SGPT (U/L) |
20/16 |
28/16 |
79/51 |
82/62 |
33/52 |
42/66 |
| Alkaline Phosphatase (U/L) |
249 |
162 |
228 |
350 |
415 |
383 |
| Creatinine (mg/dL) |
0.6 |
0.6 |
0.5 |
0.5 |
0.3 |
0.4 |
| PT (seconds)/INR |
15.4/1.275 |
|
|
13.1/1 |
|
|
| Procalcitonin (ng/mL) |
3.2 |
62.9 |
36.7 |
9.7 |
0.35 |
0.2 |
WBC, White blood cells; SGOT, Serum glutamic oxaloacetic transaminase; SGPT, Serum glutamic pyruvic transaminase; PT, Prothrombin time, INR, International normalized ratio.
Blood parameters revealed pancytopenia, which led to multiple blood transfusions for the patient. Chest X-ray was suggestive of a consolidation patch on the right side. An injection of piperacillin/tazobactam 4.5 g was started every 8th hourly IV by prolonged infusion. Monitoring of electrolytes and vital signs was continued along with conservative management. Additionally, the patient was receiving chemotherapy for ovarian malignancy.
On 7th day of admission, the patient was transferred to the intensive care unit (ICU) because of a sudden deterioration in vital signs and evidence of refeeding syndrome. Ionotropic support and oxygen support was initiated with escalation of antibiotics to meropenem 1 g IV 8th hourly by prolonged infusion. Computerized tomography (CT) scan of the chest and abdomen was performed. A pelvic collection was observed, with no leak. The pelvic collection was aspirated under ultrasound guidance and sent for culture and susceptibility testing. The pus culture showed growth of Acinetobacter baumanii, which was susceptible only to minocycline and intermediately sensitive to colistin. Injection of polymyxin-B 7.5 lac units IV were added 8th hourly. Rest supportive care was continued.
On 22nd day of admission, patient was intubated, and ionotropic support was escalated due to further deterioration in general condition and hemodynamics of patient. The patient started having frequent spikes in temperature. Cultures of blood and urine were sent. Due to a persistent fever, the CT abdomen was performed once more, and a leak was found. Antipyretics were used continuously with cold sponging and temperature monitoring. Blood culture identified the growth of a rare organism C. indologenes, which was susceptible to minocycline and intermediate susceptible to levofloxacin (Table 2). Injection Levofloxacin 500 mg IV 24th hourly was added after discussion with the microbiologist. The patient underwent additional surgery to repair the leak, including resection of terminal ileal segment with refashioning of ileostomy with a distal mucus fistula. On the first postoperative day, stoma started functioning. There were multiple blood and platelet transfusions given. On day 32nd, the patient was extubated, and ionotropic support was tapered off. The patient gradually improved and was shifted to ward. Supportive care was continued. The patient was successfully discharged with stable vital signs and good feed tolerance.
Table 2.
Antimicrobial susceptibility pattern of Chryseobacterium indologenes isolated from blood culture
|
Antimicrobials
|
Interpretation
|
| Piperacillin/Tazobactam |
R |
| Ceftazidime |
R |
| Cefoperazone/Sulbactam |
R |
| Cefepime |
R |
| Aztreonam |
R |
| Imipenem |
R |
| Meropenem |
R |
| Amikacin |
R |
| Gentamicin |
R |
| Ciprofloxacin |
R |
| Levofloxacin |
I |
| Minocycline |
S |
| Colistin |
R |
| Trimethoprim/Sulfamethoxazole |
R |
R: Resistant; I: Intermediate; S: Sensitive.
Discussion
Chryseobacterium spp. (previously Flavobacterium) is widely distributed in soil, plants, and water. It may be recovered from a variety of food items too.2,3 Even after chlorination, they can still survive in public water sources. Waterways at medical facilities may act as a potential reservoir. Therefore, a variety of contaminated medical devices, such as an endotracheal or a tracheostomy tube, indwelling venous catheters, ampoules, sink traps, feeding tubes, fluid-related equipment, and even disinfectants can serve as Flavobacterium reservoirs, serving as nidus of infection.
Chryseobacterium indologenes causes a number of uncommon human illnesses. The first clinical sample from which C. indologenes was isolated in 1993, came from a patient with ventilator-associated pneumonia.5 Low pathogenicity Chryseobacterium spp. are most likely to cause infection in hospitalized patients with associated risk factors such as underlying illness, extremes of age (newborn or elderly), immunocompromised states, the presence of indwelling intravenous devices, and long-term use of broad-spectrum antibiotics. The risk factors in the current case were ovarian cancer, presence of endotracheal tube and prolonged use of broad-spectrum antibiotics.
Flexirubin, a pigment generated by C. indologenes colonies, is converted in culture to a dark-yellow pigment (Figure 1).6,7
Figure 1.
Dark-yellow pigmentation produced by C. indologenes on Mueller Hinton Agar (left) and Blood Agar (right)
.
Dark-yellow pigmentation produced by C. indologenes on Mueller Hinton Agar (left) and Blood Agar (right)
Chryseobacterium indologenes has been found to have inherent resistance to antibiotics such as extended spectrum penicillins, carbapenems, aminoglycosides, ticarcillin-clavulanate, macrolides, and chloramphenicol. Additionally, it is resistant to aztreonam and cephalosporins (except ceftazidime and cefepime). Most studies have found that C. indologenes is still sensitive to quinolones, ceftazidime, piperacillin-tazobactam, minocycline, rifampicin, and trimethoprim-sulfamethoxazole.3,4,8 In our case, C. indologenes was also found susceptible to minocycline and levofloxacin (Table 2).
The SENTRY antimicrobial monitoring programme (1997-2001) also revealed that, glycopeptides, chloramphenicol, and linezolid are ineffective for treating infections caused by these bacteria.3 Cefoperazone-sulbactam and cotrimoxazole are considered to be the most effective drugs, particularly for bloodstream infections, as documented in a study including 215 clinical isolates of C. indologenes.8
In current case, the patient was receiving chemotherapy for ovarian cancer, when piperacillin/tazobactam treatment was initiated. The antibiotics were changed to meropenem and polymyxin B in accordance with the results of the pus culture which revealed the growth of A. baumannii. After isolation of C. indologenes on blood agar from paired blood cultures bottles, bacterial identification and susceptibility testing was done using VITEK 2 automated system using the ID-GNB cards & treatment was changed to levofloxacin according to susceptibility report. The patient responded positively to the prescribed treatment plan. The entire course of treatment was completed without any further issues.
The mortality rate for C. indologenes infections is approximately 17%.2 We suggest that C. indologenes is a bacterium that may be able to produce bacteremia in elderly patients with several co-morbidities who have had various hospital procedures, most likely as a result of a breach of infection control guidelines. Some previous studies of bacteremia caused by C. indologenes have been summarized in Table 3.
Table 3.
Review of literature of bacteremia caused by Chryseobacterium indologenes
|
Reference
|
Year of publication
|
Study design
|
No. of patients
|
Source of bacteremia
|
Immune status
|
Antimicrobial susceptibility profile
|
Treatment given
|
Outcome
|
|
9
|
2021 |
Case Report |
1 |
ND |
Immuno-Compromised (malignancy) |
Susceptible to- CFS |
CFS |
Survived |
| Resistant to- ND |
|
3
|
2020 |
Case Report |
1 |
Hemodialysis catheter |
Immuno-Compromised (ESRD) |
Susceptible to- CIP, LE, P/T, COT |
P/T |
Survived |
| Resistant to- AK, ATR, CPM, CTR, GEN, MRP, TOB |
|
1
|
2019 |
Case Report |
1 |
Central venous catheter |
Immuno-compromised (malignancy) |
Susceptible to- MIN, LE (intermediate) |
LE, MIN |
Expired |
| Resistant to- CAZ, AK, CIP, GEN, CL, CPM, MRP, ATR, TCC, IPM, CFS, COT, P/T, TGC |
|
2
|
2018 |
Case Series |
7 |
ND |
All Immuno-Compromised |
Susceptible to- MIN |
CIP (Documented for three patients) |
Expired-2 Survived-5 |
| Resistant to-AMP, AMS, CXM, CH, CL, ETP, MRP |
|
7
|
2014 |
Case Report |
1 |
Central venous catheter |
Immuno-Compromised (malignancy) |
Susceptible to- COT |
COT |
Survived |
| Resistant to-AK, GEN, CAZ, CPM, P/T, CFS, IPM, MRP, CL, TE, CIP |
AK, amikacin; A, ampicillin; AMS, ampicillin/sulbactam; AMC, amoxicillin/clavulanate; ATR, aztreonam; CPM, cefepime; CFS, cefoperazone/sulbactam; CIP, ciprofloxacin; CTR, ceftriaxone; CPM, cefepime; CH, cephalothin; CAZ, ceftazidime; CL, colistin; COT, cotrimoxazole (trimethoprim/sulfamethoxazole); CE, cefotaxime; ETP, ertapenem; GEN, gentamicin; IPM, imipenem; LE, levofloxacin; MRP, meropenem; OF, ofloxacin; PI, piperacillin; P/T, piperacillin/tazobactam; TCC, ticarcillin/clavulanic acid; TOB, tobramycin; TGC, tigecycline; TE-tetracycline; ND, Not documented.
Chryseobacterium indologenes is not widely regarded as a highly pathogenic organism; but because of the patient’s already weakened immune system and the several accompanied comorbidities, it causes number of infections and treatment was considered to be difficult due to its high resistance to various antibiotics. Most likely, it’s related to using too many antibiotics and breaking infection control regulations. In this case, the patient shown a satisfactory clinical improvement after the medication was adjusted in accordance with the antimicrobial susceptibility report.
Conclusion
In conclusion, the findings suggest that C. indologenes should be taken into consideration as a potential pathogen in cases of bloodstream infections in individuals, particularly when patient is immunocompromised and invasive procedures are being undertaken. This organism is resistant to several antibiotics; make it challenging to find the best therapeutic options. Our perspective is that blood culture results should be periodically monitored, and treatment options should be modified based on the patients’ susceptibility report and the local antibiogram data.
Acknowledgments
The authors thank the patient for showing patience and helping us improve care through the use of information.
Competing Interests
Authors declare no conflict of interest in this study.
Ethical Approval
No ethical committee approval required. Informed consent was obtained from the patient to publish this case.
References
- Bhagawati G, Bhardwaj A, Sajikumar R, Singh SP, Prajapati S. Bacteremia by Chryseobacteriumindologenes in a patient with lung cancer: a clinical and microbiological investigation. Indian J Crit Care Med 2019; 23(3):157-9. doi: 10.5005/jp-journals-10071-23142 [Crossref] [ Google Scholar]
- Alon D, Karniel E, Zohar I, Stein GY. Chryseobacteriumindologenes bacteremia: clinical and microbiological characteristics of an emerging infection. Int J Clin Med 2018; 9(6):520-7. doi: 10.4236/ijcm.2018.96045 [Crossref] [ Google Scholar]
- Izaguirre-Anariba DE, Sivapalan V. Chryseobacteriumindologenes, an emerging bacteria: a case report and review of literature. Cureus 2020; 12(1):e6720. doi: 10.7759/cureus.6720 [Crossref] [ Google Scholar]
- Chou DW, Wu SL, Lee CT, Tai FT, Yu WL. Clinical characteristics, antimicrobial susceptibilities, and outcomes of patients with Chryseobacteriumindologenes bacteremia in an intensive care unit. Jpn J Infect Dis 2011; 64(6):520-4. [ Google Scholar]
- Bonten MJ, van Tiel FH, van der Geest S, Smeets HG, Stobberingh EE, Gaillard CA. Topical antimicrobial prophylaxis of nosocomial pneumonia in mechanically ventilated patients Microbiological observations. Infection 1993; 21(3):137-9. doi: 10.1007/bf01710529 [Crossref] [ Google Scholar]
- Steinberg JP, Burd EM. Other gram-negative and gram-variable bacilli. In: Mandell GL, Bennett JE, Dolin R, eds. Principles and Practice of Infectious Diseases. 7th ed. Livingstone, Zambia: Elsevier; 2010. p. 279-95.
- Aydin Teke T, Oz FN, Metin O, Bayhan GI, Gayretli Aydin ZG, Oguz M. Chryseobacteriumindologenes Septicemia in an Infant. Case Rep Infect Dis 2014; 2014:270521. doi: 10.1155/2014/270521 [Crossref] [ Google Scholar]
- Chen FL, Wang GC, Teng SO, Ou TY, Yu FL, Lee WS. Clinical and epidemiological features of Chryseobacteriumindologenes infections: analysis of 215 cases. J Microbiol Immunol Infect 2013; 46(6):425-32. doi: 10.1016/j.jmii.2012.08.007 [Crossref] [ Google Scholar]
- Demir Gündoğan B, Sağcan F, Çağlar Çıtak E. Chryseobacteriumindologenes as a rare pathogen of bacteremia in febrile neutropenia. Trends Pediatr 2021; 2(1):43-6. doi: 10.5222/TP.2021.98608 [Crossref] [ Google Scholar]